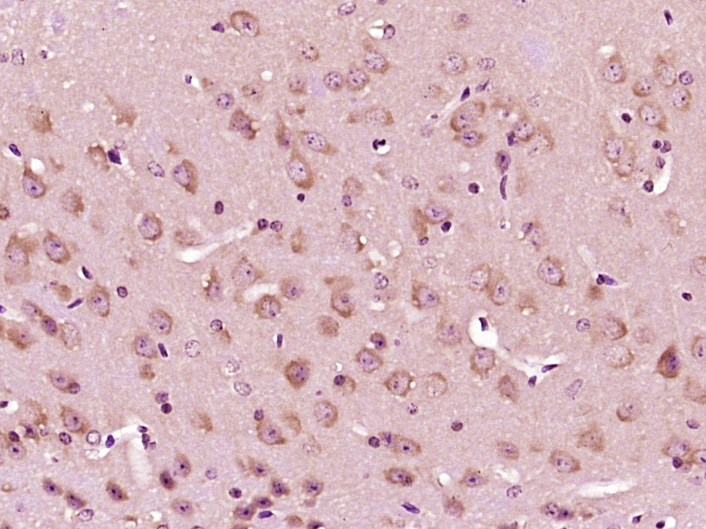
Paraformaldehyde-fixed, paraffin embedded Mouse brain; Antigen retrieval by boiling in sodium citrate buffer (pH6.0) for 15min; Block endogenous peroxidase by 3% hydrogen peroxide for 20 minutes; Blocking buffer (normal goat serum) at 37°C for 30min; Antibody incubation with SMEK1 Polyclonal Antibody, Unconjugated (bs-12636R) at 1:400 overnight at 4°C, DAB staining.

Immunofluorescent staining of human cell line MCF7 shows localization to nucleoplasm.
Anti-PPP4R3A Antibody
HPA063917
ApplicationsWestern Blot, ImmunoCytoChemistry
Product group Antibodies
ReactivityHuman
TargetPPP4R3A
Overview
- SupplierAtlas Antibodies
- Product NameAnti-PPP4R3A Antibody
- Delivery Days Customer4
- ApplicationsWestern Blot, ImmunoCytoChemistry
- CertificationResearch Use Only
- ClonalityPolyclonal
- ConjugateUnconjugated
- Gene ID55671
- Target namePPP4R3A
- Target descriptionprotein phosphatase 4 regulatory subunit 3A
- Target synonymsFLFL1, KIAA2010, MSTP033, PP4R3, PP4R3A, SMEK1, smk-1, smk1, serine/threonine-protein phosphatase 4 regulatory subunit 3A, SMEK homolog 1, suppressor of mek1
- HostRabbit
- IsotypeIgG
- Protein IDQ6IN85
- Protein NameSerine/threonine-protein phosphatase 4 regulatory subunit 3A
- Scientific DescriptionRecombinant Protein Epitope Signature Tag (PrEST) antigen sequence
- ReactivityHuman
- Storage Instruction-20°C,2°C to 8°C
- UNSPSC41116161